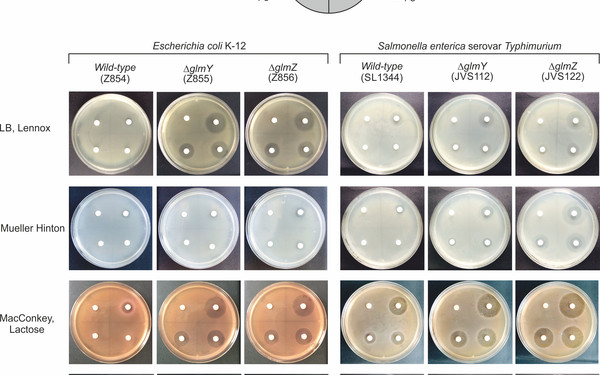

Spotlights
PhD call 2023
Boris introduces his lab and their "work horse" Escherichia coli and describes mechanisms connected to the membrane.
A novel trans-envelope signaling complex in bacteria.
We recently revealed a conserved signaling cascade acting across three different cellular compartments. The outer-membrane lipoprotein QseG activates the inner membrane-bound kinase QseE by interaction to phosphorylate a cytoplasmic response regulator. This three-component system senses a stimulus, likely derived from the cell envelope, to activate genes required for envelope synthesis and repair.
Non-canonical activation of a histidine kinase through an accessory protein.
Kinase KdpD can be activated by non-phosphorylated PtsN, a component of the PTS(Ntr), resulting in phosphorylation of response regulator KdpE. Paradoxically, PtsN and KdpE compete for binding as both contact the KdpD transmitter domain. We found that PtsN binds one protomer in the KdpD dimer to stimulate phosphorylation of the second protomer in trans, which finally phosphorylates KdpE.
A novel RNA-binding protein for programmed turnover of a small regulatory RNA.
The RNA-binding protein RapZ is part of a regulatory circuit involving the two homologous small RNAs GlmY and GlmZ, which jointly regulate synthesis of cell envelope precursor molecules. Our recent work on RapZ revealed the structure and features of a novel type of an RNA-binding protein, which allosterically activates endoribonuclease RNase E by interaction to selectively degrade GlmZ on demand.
Role of small regulatory RNAs for antibiotic resistance.
We recently discovered that small RNAs GlmY and GlmZ provide Enterobacteria including important pathogens with intrinsic resistance towards antibiotics targeting the central cell envelope synthesis enzyme GlmS. Thus, suppression of the GlmY/GlmZ circuit increases antibiotic susceptibility, which could be useful to treat infections and may help to overcome the current antibiotic resistance crisis.

Dea Slade
Dea Slade Gaia Novarino
Gaia Novarino